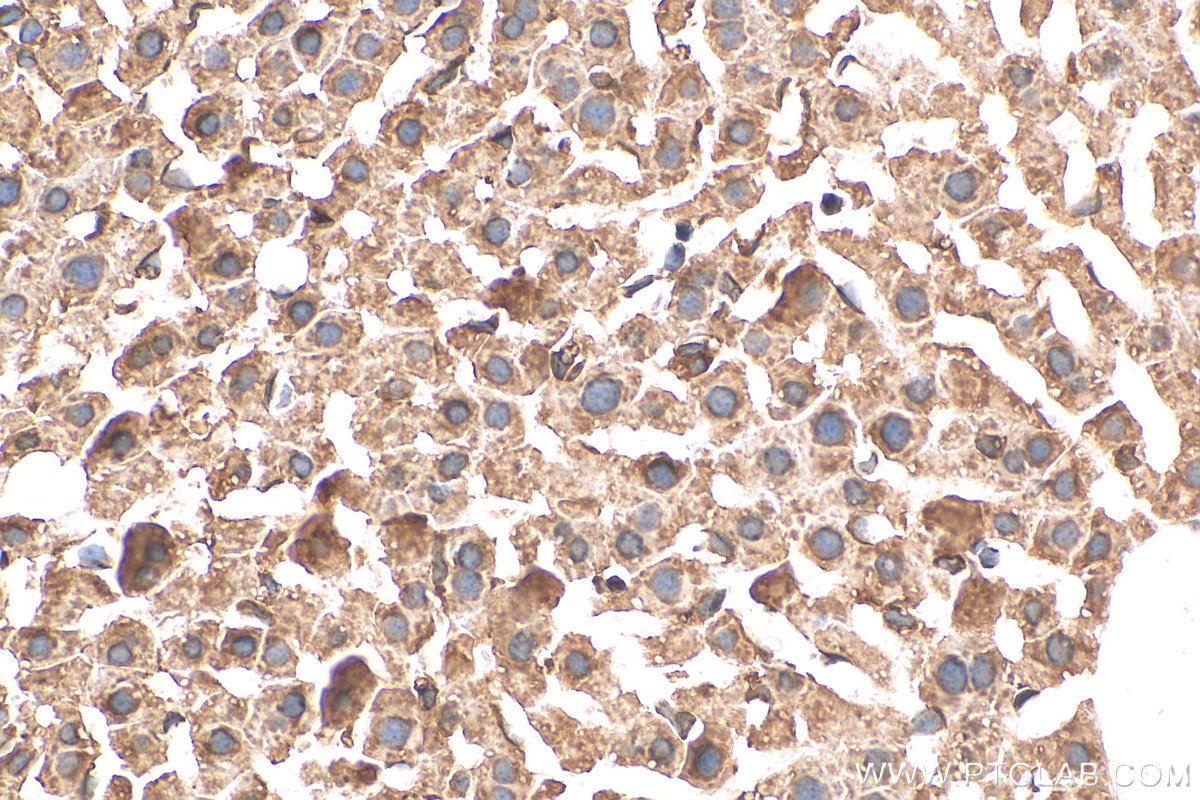

验证数据展示
经过测试的应用
| Positive WB detected in | mouse heart tissue, HEK-293 cells, mouse heart unboiled, 37°C incubated HEK-293 cells |
| Positive IHC detected in | mouse skeletal muscle tissue, mouse liver tissue Note: suggested antigen retrieval with TE buffer pH 9.0; (*) Alternatively, antigen retrieval may be performed with citrate buffer pH 6.0 |
| Positive IF-P detected in | mouse heart tissue |
| Positive IF-Fro detected in | mouse heart tissue |
| Positive IF/ICC detected in | C2C12 cells, mouse heart tissue |
推荐稀释比
| 应用 | 推荐稀释比 |
|---|---|
| Western Blot (WB) | WB : 1:5000-1:50000 |
| Immunohistochemistry (IHC) | IHC : 1:50-1:500 |
| Immunofluorescence (IF)-P | IF-P : 1:50-1:500 |
| Immunofluorescence (IF)-FRO | IF-FRO : 1:50-1:500 |
| Immunofluorescence (IF)/ICC | IF/ICC : 1:200-1:800 |
| It is recommended that this reagent should be titrated in each testing system to obtain optimal results. | |
| Sample-dependent, Check data in validation data gallery. | |
产品信息
27311-1-AP targets SERCA2/ATP2A2 in WB, IHC, IF/ICC, IF-P, IF-Fro, ELISA applications and shows reactivity with human, mouse samples.
| 经测试应用 | WB, IHC, IF/ICC, IF-P, IF-Fro, ELISA Application Description |
| 文献引用应用 | WB, IHC, IF |
| 经测试反应性 | human, mouse |
| 文献引用反应性 | human, mouse |
| 免疫原 |
CatNo: Ag26177 Product name: Recombinant human SERCA2,ATP2A2 protein Source: e coli.-derived, PGEX-4T Tag: GST Domain: 314-580 aa of BC035588 Sequence: VITTCLALGTRRMAKKNAIVRSLPSVETLGCTSVICSDKTGTLTTNQMSVCRMFILDRVEGDTCSLNEFTITGSTYAPIGEVHKDDKPVNCHQYDGLVELATICALCNDSALDYNEAKGVYEKVGEATETALTCLVEKMNVFDTELKGLSKIERANACNSVIKQLMKKEFTLEFSRDRKSMSVYCTPNKPSRTSMSKMFVKGAPEGVIDRCTHIRVGSTKVPMTSGVKQKIMSVIREWGSGSDTLRCLALATHDNPLRREEMHLEDS 种属同源性预测 |
| 宿主/亚型 | Rabbit / IgG |
| 抗体类别 | Polyclonal |
| 产品类型 | Antibody |
| 全称 | ATPase, Ca++ transporting, cardiac muscle, slow twitch 2 |
| 别名 | ATP2A2, SERCA2, SERCA2,ATP2A2, SERCA2b, ATP2A 2 |
| 计算分子量 | 1042 aa, 115 kDa |
| 观测分子量 | 110-115 kDa |
| GenBank蛋白编号 | BC035588 |
| 基因名称 | SERCA2 |
| Gene ID (NCBI) | 488 |
| RRID | AB_3085945 |
| 偶联类型 | Unconjugated |
| 形式 | Liquid |
| 纯化方式 | Antigen affinity purification |
| UNIPROT ID | P16615 |
| 储存缓冲液 | PBS with 0.02% sodium azide and 50% glycerol, pH 7.3. |
| 储存条件 | Store at -20°C. Stable for one year after shipment. Aliquoting is unnecessary for -20oC storage. |
背景介绍
ATP2A2, also known as SERCA2 (Sarco/endoplasmic reticulum-type calcium transport ATPase 2), is a 110 kDa magnesium-dependent enzyme catalyzing the hydrolysis of ATP coupled with the translocation of calcium from the cytosol to the sarcoplasmic reticulum lumen. Human SERCA2 gene gives rise to several alternatively spliced isoforms: SERCA2a, SERCA2b and SERCA2c. ATP2A2 is mainly expressed in the sarcoplasmic reticulum of muscle cells and the endoplasmic reticulum of most cell types.
实验方案
| Product Specific Protocols | |
|---|---|
| IF protocol for SERCA2/ATP2A2 antibody 27311-1-AP | Download protocol |
| IHC protocol for SERCA2/ATP2A2 antibody 27311-1-AP | Download protocol |
| WB protocol for SERCA2/ATP2A2 antibody 27311-1-AP | Download protocol |
| Standard Protocols | |
|---|---|
| Click here to view our Standard Protocols |
发表文章
| Species | Application | Title |
|---|---|---|
Life Sci Trimethylamine N-oxide induces cardiac diastolic dysfunction by down-regulating Piezo1 in mice with heart failure with preserved ejection fraction | ||
Am J Physiol Lung Cell Mol Physiol Role of voltage-gated Ca2+ channels and Ano1 Ca2+-activated Cl- channels in M2 muscarinic receptor-dependent contractions of murine airway smooth muscle | ||
JCI Insight Critical role of Znhit1 for postnatal heart function and vacuolar cardiomyopathy. | ||
Nat Commun ER calcium depletion as a key driver for impaired ER-to-mitochondria calcium transfer and mitochondrial dysfunction in Wolfram syndrome | ||
Biochem Biophys Res Commun Mitigation of ROS-triggered endoplasmic reticulum stress by upregulating Nrf2 retards diabetic nephropathy | ||
FASEB J Pilocarpine mediated excessive calcium accumulation leads to ciliary muscle cell senescence and apoptosis |